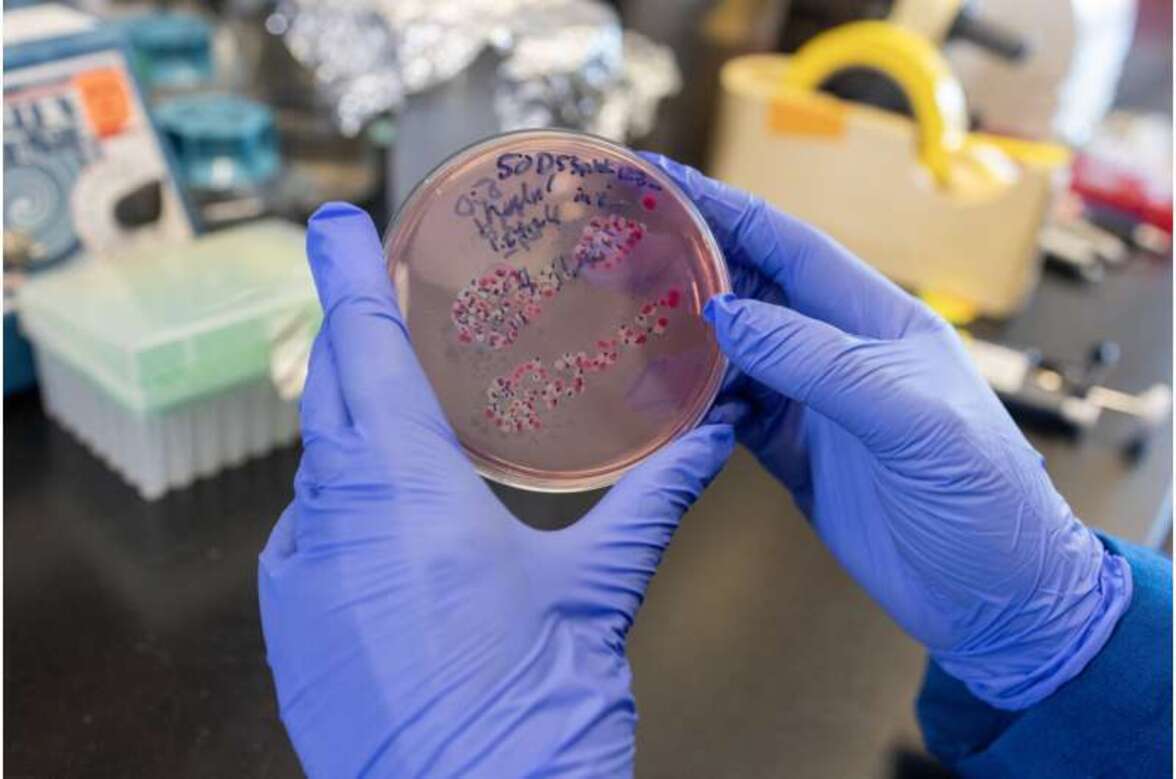
Как дисбаланс микробиома кишечника усугубляет хроническую болезнь почек

Исследователи из Медицинской школы Калифорнийского университета в Дэвисе выяснили, как дисбаланс кишечного микробиома усиливает выработку побочных продуктов обмена веществ некоторыми кишечными бактериями.
Этот дисбаланс запускает цикл обратной связи, усугубляющий хроническую болезнь почек (ХБП) у мышей. Ученые определили экспериментальный препарат, который может разорвать этот разрушительный цикл. Результаты исследования опубликованы в журнале Science. Ученые показали, что нарушение функции почек приводит к повышению уровня нитратов в толстой кишке. Нитраты стимулировали выработку E. coli индола — органического соединения, которое превращается в вредный продукт распада — индоксилсульфат, — который еще больше повреждает почки. Блокирование выработки одного фермента в кишечнике — индуцируемой синтазы оксида азота (iNOS) — позволило остановить этот разрушительный цикл.
«Предыдущие исследования показали, что хроническая болезнь почек связана с повышенным содержанием Enterobacteriaceae в кале», — сообщил первый автор исследования Джи-Йон Ли. «В этом исследовании нитраты хозяина выявлены как фактор, превращающий обычные кишечные бактерии, такие как E. coli, в производителей индола, способных ускорить развитие хронической болезни почек», — сообщил Ли.
По оценкам, в 2023 году в мире около 788 миллионов человек страдали ХБП. Для людей с почечной недостаточностью гемодиализ является спасительной процедурой, позволяющей удалять из крови продукты обмена веществ и избыточную жидкость. Однако индоксилсульфат не удаляется при диализе, поскольку он связывается с сывороточным альбумином. Повышенные уровни индоксилсульфата в сыворотке крови связаны с более тяжелым течением хронической болезни почек. «Выявив фактор, ответственный за рост количества энтеробактерий при хронической болезни почек, и продемонстрировав важность этих бактерий для производства индола и прогрессирования заболевания, наши исследования указывают на iNOS как на потенциальную мишень для стратегий вмешательства», — сообщил Ли.
Исследователи провели испытания определенных штаммов E. coli на мышах. Они также провели анализ образцов кала людей с ХБП и без неё. У мышей они обнаружили:
- Нарушение функции почек приводило к усилению транскрипции гена Nos2 (гена, ответственного за синтез iNOS) в слизистой оболочке толстой кишки.
- Повышенный уровень iNOS приводил к увеличению количества оксида азота, который вступал в реакцию с кислородными радикалами с образованием нитратов.
- Повышенный уровень нитратов стимулировал рост E. coli, что приводило к увеличению выработки индоксилсульфата — токсина для почек, создавая разрушительную петлю обратной связи.
В дополнение к результатам, полученным на мышах, исследователи обнаружили, что образцы кала людей с ХБП демонстрировали тот же эффект, что и у мышей. Хотя образцы кала людей с заболеванием почек показывали более высокие уровни E. coli, выработка индола увеличивалась только при добавлении нитратов по сравнению со здоровыми людьми. Чтобы определить, может ли снижение уровня iNOS улучшить результаты у мышей, исследователи протестировали аминогуанидин — препарат, известный своим ингибирующим действием на iNOS. У мышей, которым вводили аминогуанидин, наблюдалось снижение уровня нитратов в слизи, снижение уровня индоксилсульфата и улучшение показателей функции почек.

Хотя результаты обнадеживают в плане поиска механизма снижения уровня индоксилсульфата — и потенциального замедления прогрессирования заболеваний почек — исследователи отмечают ряд ограничений. Поскольку кишечные бактерии человека отражали нитрат-зависимый всплеск индола у мышей, потребуются дополнительные исследования для подтверждения полученных результатов у людей. Также необходимы клинические испытания, чтобы проверить, могут ли ингибиторы iNOS или другие агонисты и ингибиторы безопасно снижать уровень индоксилсульфата и улучшать исходы у людей с ХБП. И, наконец, исследователи отмечают, что экосистема кишечника сложна: E. coli — не единственная кишечная бактерия, продуцирующая индол, и длительное подавление нитратных путей может повлечь за собой неизвестные последствия.
«Это исследование показывает, что изменение кишечной среды — а не только самих микробов — может оказать существенное влияние на прогрессирование заболевания», — сказал Ли. «Тем не менее, воздействие на пути хозяина, которые формируют метаболизм микробов, может стать новым способом лечения хронической болезни почек».